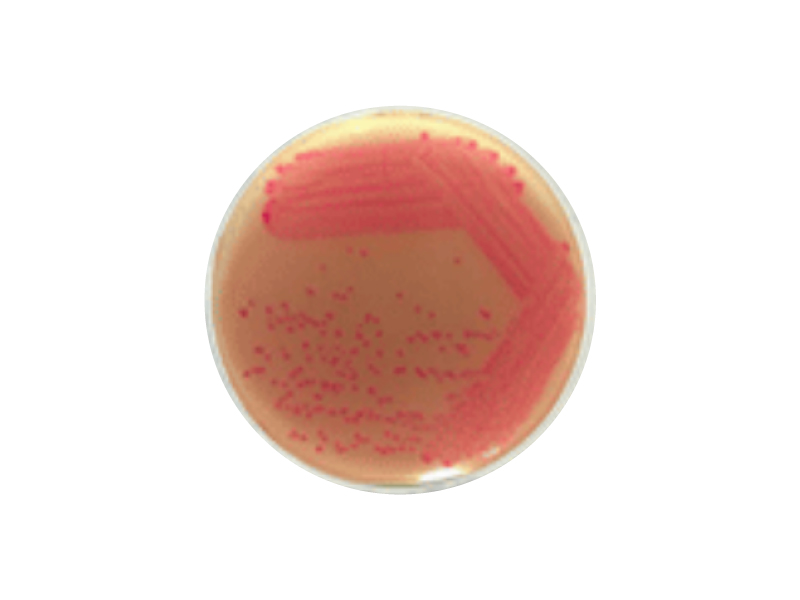

2025/02/13 Biolog 呈色培養基 Rainbow® Agar 現貨供應中

BIOLOG 呈色培養基 Rinbow® Agar,台灣現用現貨供應中!
Rainbow® Agar 是一種簡單的選擇性顯色培養基,可幫助您方便快速檢測出 E. coli O157、Shigella 和 Aeromonas,並在 24 小時內獲得結果!
![]() |
Rainbow Agar O157 E. coli O157 |
![]() |
Rainbow Agar Shigella/Aeromonas Shigella spp. |
了解更多 >>>